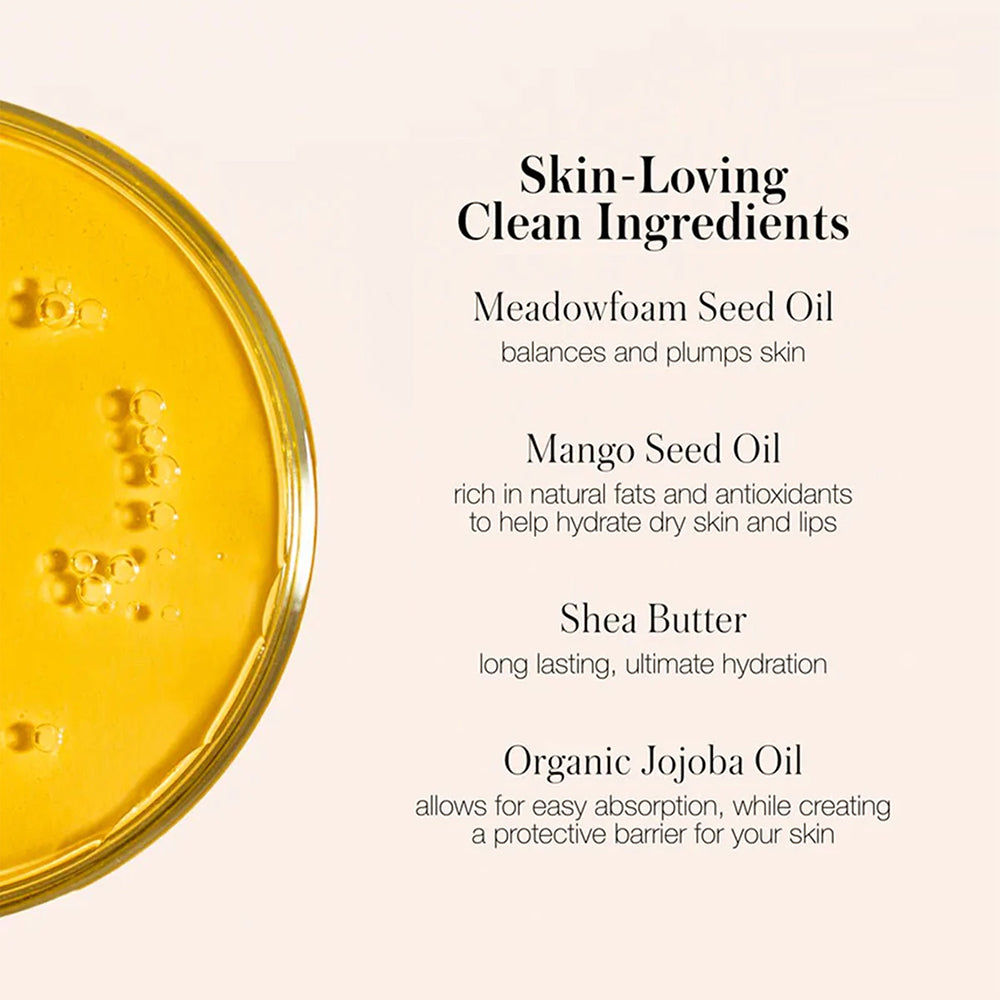
product-thumbnail

RMS Beauty Go Nude Lip Pencil-Sunrise Nude(1 pc)
97AED 7325% Off
Including VAT
Pay 4 interest-free payments of AED 18.25
Delivery Options
Check delivery date
Genuine Products 100%
100% Authentic, directly purchased from RMS Beauty.
Easy Return Policy
Products can be returned within 15 days of delivery. Products are eligible for returns only in their original packaging and in a sealed condition. Opened or used products will not be accepted as returns.
Sold by: Nysaa Beauty LLC